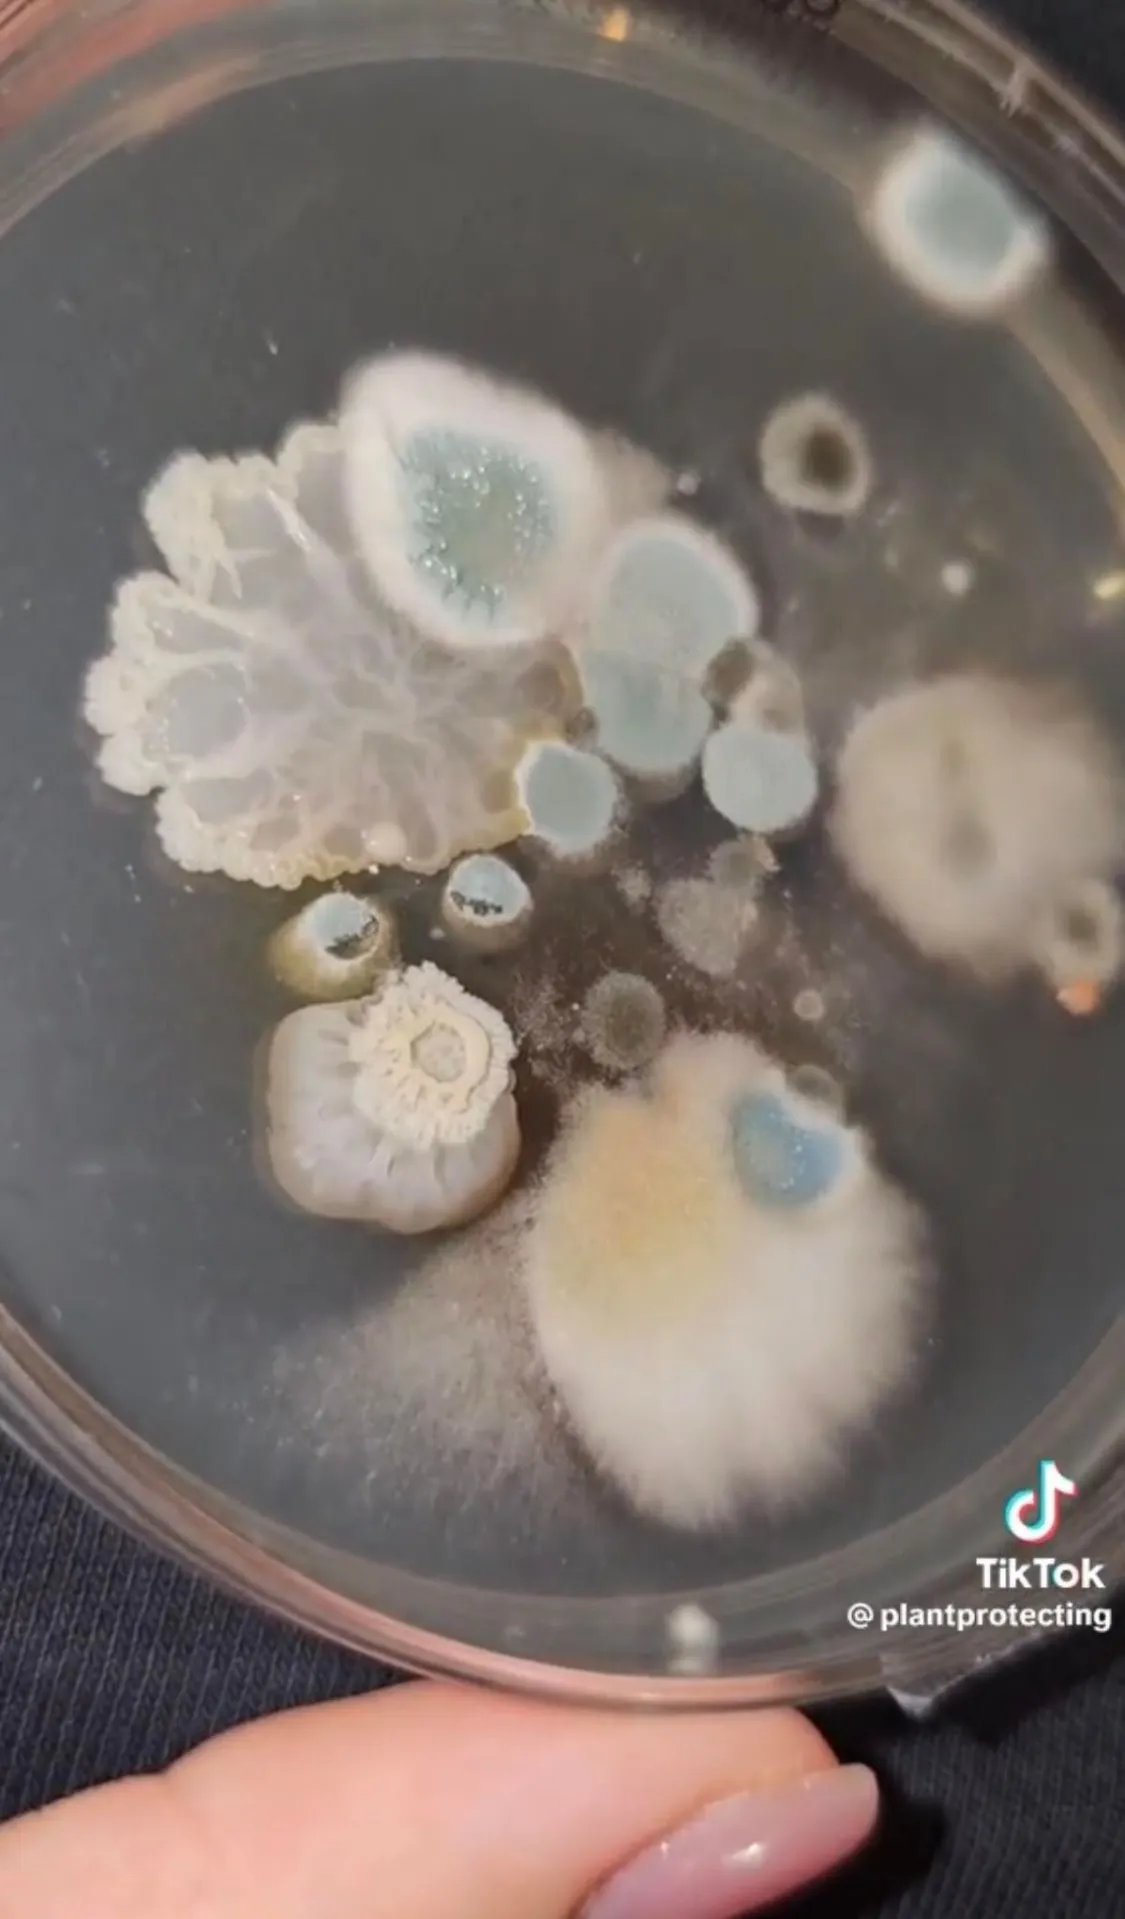
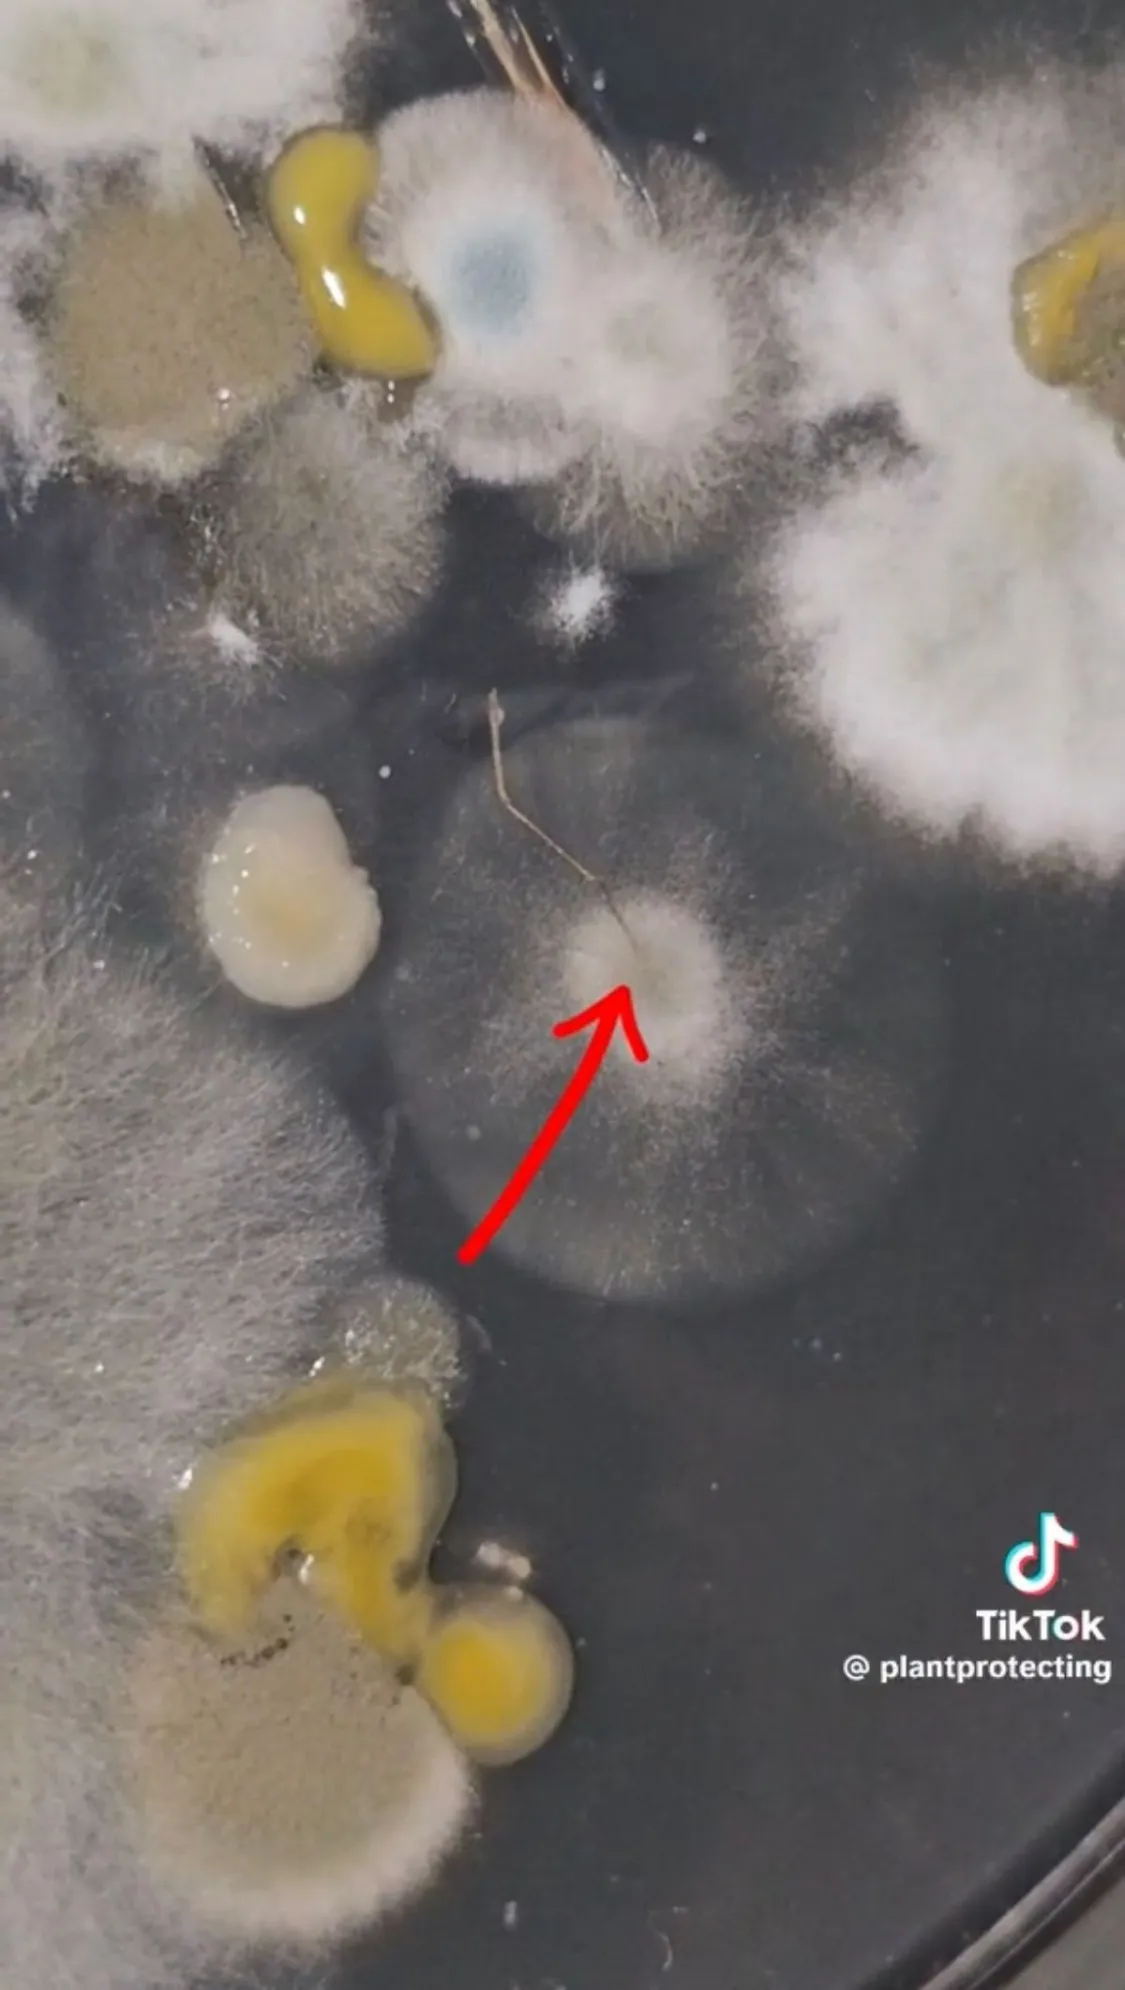

Mutatjuk a TikTok kedvenc növényorvosának legérdekesebb kísérleteit – Videó
Nem is gondolnád, hogy a mindennapokban mennyi kis élőlénnyel kerülsz kapcsolatba. Gyuris Rita tárgyakról és élelmiszerekről vett mintái megmutatják a megdöbbentő igazságot.
Gyuris Rita növényorvos a plantprotecting nevű TikTok-csatornáján előszeretettel tenyészt ki különféle tárgyakból, vagy élelmiszerből gomba- és baktériumtelepeket. Összegyűjtöttük a legérdekesebb kísérleteit.

Bolti zsemle
"Az első napon egy baktériumkolónia nőtt fel, de a harmadik napra már megjelent a többi baktériumkolónia és gombatelep is" – állapította meg. Rita szerint egyértelmű, hogy a zsömlén található baktériumok az emberek koszos kezéről kerültek a pékárura. A növényorvos megnyugtatta követőit, hogy ezek a mikroorganizmusok nem veszélyesek az emberre nézve.
A péktermékek egyébként pont az a kategória, amit szeret mindenki jól összefogdosni, hogy a legszebbet tudja kiválasztani. A válogatással egyébként nem lenne probléma, hogyha ezt nem a koszos kezünkkel tennénk, ugyanis nyilvánvaló, hogy ezek a kezünkről kerülnek oda. Ezek a mikroorganizmusok egyébként nem veszélyesek ránk nézve, főleg nem egy egészséges immunrendszernek. Na meg persze ott a gyomorsav.
Lecsapott szúnyog
"Az első napra ránézésre ugyanolyan baktériumok jelentek meg, illetve a szúnyog testéből kinőtt egy gomba. A harmadik napra már két-három féle baktérium is megjelent, valamint több gombatelep is. Számomra az eredmény azért sem meglepő, mert a szúnyogok rengetegféle emberrel érintkezhetnek, illetve rengeteg tárgyunkra is rászállnak, vagy akár a falra, ami tele lehet gombaspórákkal. A mikroorganizmusok az életünk részei, azért, mert nem látjuk őket, az nem jelenti azt, hogy nincsenek ott. Amit tehetsz, hogy, ha lecsapsz egy szúnyogot, akkor mosd meg utána a kezed!" – tanácsolta a növényorvos.
4-es 6-os villamos
„A korábbi vizsgálataimhoz viszonyítva semmi meglepő eredményt nem mutatott a táptalaj” – nyugtatott meg mindenkit a növényorvos.
Hasonló mennyiségű mikroorganizmus él a kezeinken is, sőt az otthon lapuló tárgyakon is, mint például a kapcsoló, a játékkonzol, a telefonok, a laptop. Mivel a közlekedési eszközöket napi szinten tízezrek használják, természetes, hogy ennyi minden felnőtt a táptalajokon
– mondta korábban a Metropolnak Rita. Szerinte azonban a tenyészetből ránézésre nem lehet megmondani, hogy ezek a mikroorganizmusok pontosan micsodák, ehhez komolyabb laborvizsgálatok kellenének.

Frissen hullott hó
Szerintem ez egy meglepően jó eredmény, én sokkal rosszabbra számítottam, ugyanis baktérium egyáltalán nem nőt fel
– állapította meg a szakember. "Ezek a gombák, melyek a táptalajban szaporodásnak indultak, nagy valószínűséggel a levegőben voltak benne. Azért persze a nyelvemmel nem kapnám el a hópehelyeket, de szerintem ez egy egész jó eredmény."






